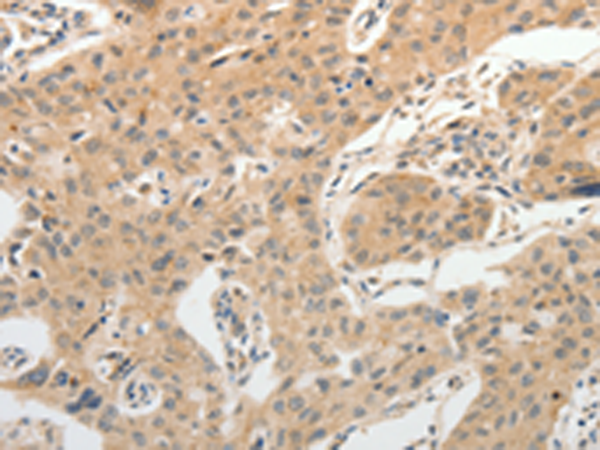
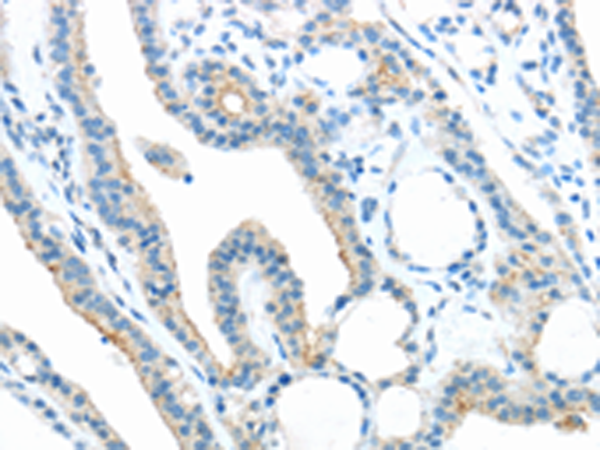

-
分类: 科研抗体货号: P11172别名:应用: IHC反应种属: Human, Mouse
-
分类: 科研抗体货号: P11170别名: PAQR2; ACDCR2应用: IHC反应种属: Human, Mouse
-
分类: 科研抗体货号: P11188别名: PITK; FAP79; CFAP79; PPP1R65应用: WB反应种属: Human, Mouse
-
分类: 科研抗体货号: P11167别名: DSH; AGS6; G1P1; IFI4; P136; ADAR1; DRADA; DSRAD; IFI-4; K88DSRBP应用: IHC反应种属: Human
-
分类: 科研抗体货号: P11175别名:应用: IHC反应种属: Human
-
分类: 科研抗体货号: P11187别名: ANKRA应用: IHC反应种属: Human, Mouse
-
分类: 科研抗体货号: P11166别名: ADAM-TS6; ADAMTS-6; ADAM-TS 6应用: IHC反应种属: Human
-
分类: 科研抗体货号: P11174别名: AYTL3; AGPAT7; LPEAT2; LPAAT-eta应用: WB,IHC反应种属: Human, Mouse
-
分类: 科研抗体货号: P11186别名:应用: IHC反应种属: Human
-
分类: 科研抗体货号: P11165别名:应用: WB反应种属: Human, Mouse, Rat

鄂公网安备42018502007531号
鄂公网安备42018502007531号

